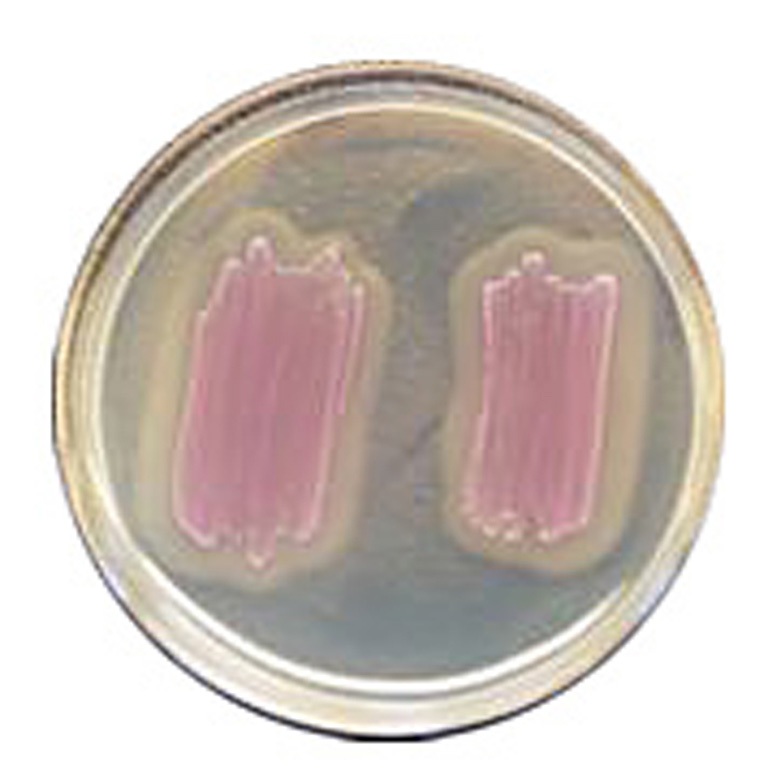

Über das Produkt
Chromogenes Medium zur Bestätigung von L. monocytogenes Arten aus verdächtigen Kolonien auf CHROMagar Listeria.
Produkte
Mikrobiologie
CHROMagar™ - Trockennährmedien
CHROMagar Listeria ID (250 mL) - ohne CE
CHROMagar Listeria ID (250 mL) - ohne CE
Chromogenes Medium zur Bestätigung von L. monocytogenes Arten aus verdächtigen Kolonien auf CHROMagar Listeria.